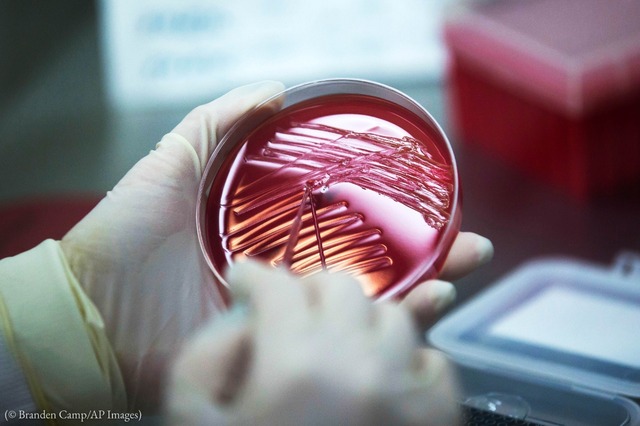
CDC

-
Primeros registros sobre el suicidio en las civilizaciones antiguas.
-
- Se han perdido fragmentos.
- Constituido por 4 poemas del estado mental del suicida. +Padecía una depresión grave con problemas de síntomas psicóticos +Ideas de auto denigración +Rumiación de ideas suicidas. Descripción sobre la enfermedad depresiva y sobre la primera nota suicida que se conoce en la historia del ser humano.
-
Los seguidores de Pitágoras consideraban que el cuerpo era la prisión del alma, considerado a su vez un regalo de los dioses y al ser liberada a través del suicidio, iría en contra de los dioses y por lo tanto sería castigado
-
Supuso la primera representación legal de una conducta derivada de un estado mental alterado («non compos mentis») y recogía como atenuante en la mente del suicida la perturbación de sus facultades mentales.
-
El suicidio era visto como lago indigno y vergonzoso, por lo cual el cadáver del suicida era castigado amputándole partes del cuerpo. Además, el tratamiento de estos cuerpos era no ser enterrados ni incinerados, debido a que estos muertos por se suicidas carecían de estatus. Por ejemplo, en las ciudades de Tebas o Chipre, los cadáveres eran arrojados al otro lado de la frontera.
El suicidio voluntario de los ancianos, era una práctica que señalaba la costumbre de eliminar la edad senil. -
Condenaba al suicidio y lo consideraba una ofensa grande hacia los dioses, además de crimen contra la sociedad. Tenía como propuesta castigos ante los suicidas como: entierros sin honores en áreas deshabitadas y en tumbas con epitafios sin identificación
-
La prohibición del suicidio no era absoluta de tratarse de un acontecimiento muy grave, que implicara el llegar hasta estas instancias como lo son: casos de enfermedades incurables o la angustia insoportable provocada por la venganza, solo bajo estas situaciones, era respetados y no condenados por el senado.
-
Rechazaba el suicidio y considera a quien lo practicara como alguien cobarde que no sabe afrontar las dificultades de la vida, además pensaba que el suicida no solo se dañaba a si mismo, sino también a su patria y a la sociedad entera.
Gracias a él, surge la inclusión del suicidio en la temática legislativa y se implementa sanciones a quienes intentara terminar con su vida. -
Diferentes escuelas filosóficas plantean un cambio en la concepción de la conducta suicida, debido a la modificación en la concepción filosófica.
El suicidio para esta escuela esta asociado a la libertad humana, esta concepción fue formulada inicialmente por los estoicos y luego por los epicúreos y los cínicos, quienes consideraban que uno podía abandonar la vida cuando esta se volvía insoportable. -
El suicidio era frecuente. El motivo de suicidarse se clasificar en aquellos debido a la furia, la edad avanzada, siempre ligado por enfermedad y debilidad, no obstante se relaciona con evitar las dificultades que devienen a partir de la prexistencia de una enfermedad como: dolor físico, vergüenza y desesperanza.
-
Los métodos empleados para el acto suicida tenían importancia, desde el punto de vista simbólico. Los mas usaos eran la inanición, el uso de armas, el envenenamiento, cortándose las venas y el ahorcamiento. De esta manera su cuerpo no podía ser deshonrado públicamente.
El suicidio no se consideraba un crimen o un pecado contra los dioses, y, se consideraba justificable y pragmático, en algunos casos; Por ejemplo, Cleopatra, Marco Antonio, Catón el Joven o Séneca. -
Sin embargo, el suicidio fue explícitamente prohibido para esclavos, legionarios y los acusados de algún delito penado con la muerte. Los esclavos, al ser «propiedad». Finalmente, el suicidio era aceptable en ciertas circunstancias como: el amor, el honor, el patriotismo y la enfermedad.
-
Para ellos fue considerado el suicidio como un acto condenable por lo cual se le negaba la sepultura, se le destruía su testamente y se confiscaban los bienes de las personas que no tenían un motivo justificable.
-
Máximo representante latino del estoicismo y defensor de la
ascesis del alma, legitimaba el suicido al considerarlo un acto de valentía y de máxima expresión de libertad humana. -
Preconcepción del suicidio en la cultura Maya e Inca
-
Decididos a poner fin a la gran revuelta judía contra su dominio, los romanos sitiaron la fortaleza de Masada. En esta época se da el suicidio colectivo de varias personas debido a que durante un asedio su rey les convenció que era preferible morir antes de ser un esclavo, así ordenó a los soldados matarse entre sí, pues el suicidio en la religión judía es prohibido.
-
Los Mayas consideraban que los curas, los guerreros que fallecían luchando, las mujeres que morían durante el parto y rodo individuo que se sacrificara a los dioses, llegaría al paraíso. Por lo tanto, el suicidio era considerado una conducta honorable y estaba relacionada a la naturaleza humana. Adorbaban Ixtab (Diosa de la muerte, el suicidio y la horca).
-
Ixtab, era representada con un cuerpo suspendido en el aire, colado, con los ojos cerrados. En su rostro refleja cierta felicidad y sus pies y manos muestran una postura de mediación. Su deber era proteger a la gente que se suicidaba, acompañando y guiando sus almas al paraíso.
El culto a Ixtab, según los documentos históricos apunta a que impulsaba a los mayas a suicidarse antes de sufrir el dominio de los conquistadores españoles. -
Contemporánea a la Maya, y consideraban que el suicidio era un derecho religioso, además creían que después de la muerte existían una vida similar a la terrenal, es por esto que cuando un emperador o personaje importante moría, necesitaba ser acompañado por sus seres queridos, por lo que estos se suicidaba.
-
Luego del Concilio de Arlés, la Iglesia condenó el suicidio oficialmente y a partir del Concilio de Toledo se decreta la excomunión para los suicidas y se les niega la aplicación de los rituales ordinarios de la Iglesia tras su muerte. Es entonces, a partir de la imposición de la idea de que los cristiano debían aceptar la vida y la muerte como una decisión divina, concepto que perdura hasta la actualidad.
-
En Grecia y Roma, se contemplaban y aceptaban algunos suicidios, pero para el siglo V, la postura se radicalizo. Debido a la fuerte tradición cristiana, y condenatoria del suicidio, explica la reducción de los suicidios de la época. Una situación similar ocurría en Oriente, ya que en el Corán considera el suicidio como el delito mas grave. Para sus finales, se flexibilizaron las leyes penales y se dio comprensión hacia los suicidios cometidos por determinados grupos como los enfermos mentales.
-
Fue el primero en considerar el acto suicida como un acto contra la Ley Natural, por lo cual era considera como un pecado similar al homicidio.
-
La confiscación de todas las propiedades del suicida, se les negaba la sepultura en Tierra Santa y el cadáver sufría todo tipo de humillaciones. Fue considerado con crudeza y rechazo sufrió el suicida, fue sin duda en el medievo. Alguno de los ejemplos de como se trataban a los suicidad son: arrastrar el cuerpo, mutilarlo, clavarle una estaca, enterrarlo en un cruce de caminos, vejarlo o negarle sepultura, se usaba como lección para el pueblo, para que este desistir de la idea del suicidio.
-
Uno de los pensadores mas influyentes de la época, mantuvo la idea de San Agustín considero al suicidio como un pecado, argumentaba que el hombree no puede disponer libremente de su vida ya que esta le pertenece a Dios.
-
Aparece la palabra "suicidio"
-
Aparecieron un grupo de humanistas filósofos que comenzaron
a cuestionar abiertamente las posiciones teológicas sobre el suicidio. con la aparición del racionalismo francés, la condena social
hacia el suicidio se redujo notablemente. Se empieza a tolerar y a mantener una actitud compasiva hacia el acto suicida. -
Jorge Robledo entra al valle de Aburrá encuentra docenas de indígenas colgados de los árboles, ahorcados con sus propias mantas
-
el libro escrito por Burton fue uno de los primeros ensayos que claramente asocio el suicidio a la depresión "¿Las causas? Puede ser una falla en el cerebro, una descomposición en la temperatura del cuerpo, una feroz hipocondría. Puede ser provocada por los ángeles, las musas, el diablo, las brujas, las estrellas. Feliz de aquel
-dice Burton- que encuentre la causa iniciadora entre todas las causas" -
El hara kiri (hara: estómago, kiri: cortar) o seppuku (desentrañamiento), es una forma de suicidio casi exclusivo de la cultura japonesa, ritual llevado a cabo por la clase de los samuráis. Consistía en inferirse un corte en el abdomen, topografía donde consideraban se consagraba el alma
-
El suicidio deja de ser penalizado como un hecho criminal y las legislaciones respecto a este tema se tornan mas blandas. Voltaire y Hume, la idea de la libertad humana y del derecho del hombre para poder acabar con su vida con total libertad y que, junto con otros autores como Rousseau y Montesquieu, se sientan las bases de la justificación filosófica de la autodeterminación hacia la muerte.
-
"Sobre el suicidio" lo legítima como un hecho de la libertad individual, oponiéndose a postulados donde el suicidio es transgresión de los deberes para con Dios o que el suicida atente contra la sociedad, sino que deja de producirle un bien.
Es falsa la suposición de que el Todopoderoso dispone de la vida de los hombres y de que sea un acto criminal el que un hombre disponga de su vida. -
El psiquiatra francés Esquirol, los primeros conceptos sobre el
suicidio desde una perspectiva psicopatológica. Explica que el suicidio se configura mediante las mismas incertidumbres que afectan a las enfermedades mentales. -
Se publica la primera sistematización sociológica en el estudio del suicidio, con la publicación de la obra de Émil Durkheim, “El Suicidio”. Estableció tres tipos fundamentales de suicidio. El suicidio egoísta, el suicidio altruista y el suicidio anómico, la situación social que atraviesa un individuo cuya integración en sociedad está severamente alterada.
-
Se visualiza la teoría del suicidio como hecho psicopatológico, el debate moral y religioso cede terreno al ámbito médico. El comienzo del desarrollo psicopatológico, ligado a la metodología científica, coincide con la secularización de la ley, lo que permitió el desplazamiento del enfoque condenatorio teológico y moral hacia la teoría del suicidio como hecho psicopatológico. Va abrazando con éxito para algunos u oprobio para otros el suicidio como una enfermedad y sobre todo de índole mental.
-
Presidido por Aaron Beck, del Instituto Nacional de Salud Mental de Estado Unidos, destaca la necesidad de realizar una nomenclatura universal. El comité propone dividir el fenómeno del suicidio en tres clases: suicidio, intento de suicidio e ideas suicidas.
-
El Centro para el Control de Enfermedades (Center for Disease Control, CDC) crea los “Criterios Operativos para la Determinación del Suicidio”
-
El manual estadístico de clasificación DSM-IV-TR, incluye a la suicido (ideación e intento) desde una perspectiva de modelo categorial, lo que significa que la conducta suicida se encuentra clasificada como síntoma de un trastorno mental.
-
Suicidio por motivos religiosos y políticos, dicha práctica puede no estar en muchas, o todas, de las doctrinas religiosas, el simple hecho de su predicación por parte de algunos líderes espirituales, normalmente extremistas, hace que cientos de seguidores estén dispuestos a dar su vida.
-
En los últimos años el suicidio ha cambiado con respecto a su percepción así como su legislación, se visualiza como una problemática social, que afecta a la sociedad, que requiere atención inmediata, creado políticas Publicas tanto regionales como mundiales para la atención.
-
María Pulgarín Zapata
Susana Blanco Vélez
Verónica Moreno Vera
A list shows items. A timeline shows sequence.
Use Timetoast to make dates, milestones, and turning points easier to understand in a clear visual format. Timetoast is a timeline maker for work, school, research, and stories.